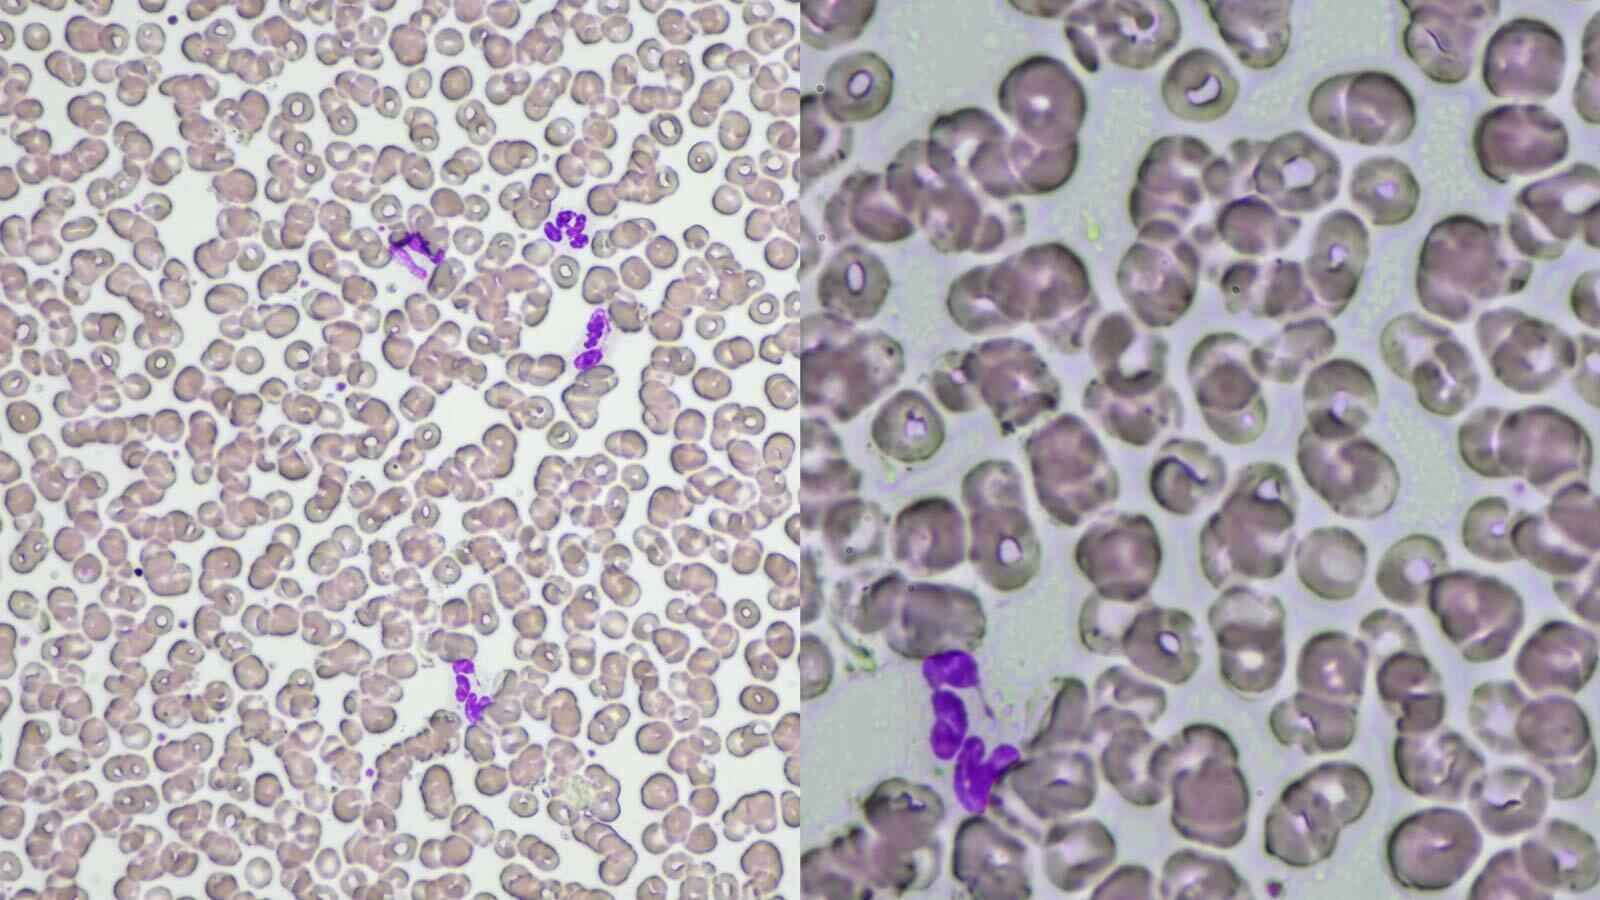
Product image

ECLIPSE Ci-L Plus

Gallery
Overview
The Nikon ECLIPSE Ci‑L plus is a refined upright biological microscope built for comfort and productivity during long observation sessions. Developed by Nikon with a strong focus on reducing operator fatigue, this model uses a smart Light Intensity Management (LIM) system that remembers and restores preferred LED brightness settings for each objective. This feature eliminates sudden fluctuations in illumination when switching magnifications, helping to ease eye strain.
Ergonomics is another highlight: the microscope’s design supports a natural posture with an adjustable eyepiece tube (tilt and extension), a height‑adjustable stage handle, and an optional nosepiece spacer to lower stage height. A built‑in status display shows key parameters — magnification, brightness, LIM status, and ECO mode — right at the base, so you don’t need to change your posture to check them.
Under the hood, the Ci‑L plus is equipped with a long-lifetime, high-luminance LED (eco‑illumination) that provides uniform, stable light across the field, while producing very little heat. The base also houses an image‑capture button that, when paired with Nikon’s recommended camera and NIS‑Elements L software, allows seamless acquisition without breaking focus. For efficient imaging workflows, the microscope can automatically adjust the scale bar on your screen in response to changes in magnification — ideal when coupled with a Nikon camera and software.
Beyond standard brightfield, the Ci‑L plus supports a variety of observation modes, including phase contrast, darkfield, simple or color polarizing, and epi-fluorescence (with optional attachments). Overall, it combines Nikon’s optical quality with user-centric features to make extended observations more manageable, precise, and reproducible.
Specifications
-
Optical System
-
CFI60 Infinity‑corrected optical system
-
-
Illumination
-
High‑luminance white LED with a built-in fly-eye lens
-
Light Intensity Management (LIM): stores brightness levels per objective and recalls them automatically
-
Power-save modes: ECO mode and Sleep mode
-
-
Controls
-
Image-capture button on the base for easy snapshotting
-
-
Eyepieces
-
Sleeve diameter: Φ 30 mm
-
Compatible eyepieces:
-
CFI 10× (F.O.V. 22 mm)
-
CFI 12.5× (16 mm)
-
CFI 15× (14.5 mm)
-
CFI UW 10× (25 mm)
-
-
-
Focusing
-
Coaxial coarse/fine focusing
-
Stroke: 30 mm total
-
Coarse: ~ 9.33 mm per rotation
-
Fine: 0.1 mm per rotation
-
Fine movement scale: 1 µm
-
Adjustable coarse torque, plus a refocusing function
-
-
Viewing Tubes
-
F.O.V. 22 mm:
-
C‑TB binocular tube
-
C‑TE2 ergonomic binocular tube (inclination 10–30°, extension up to 40 mm) via optional DSC ports
-
-
F.O.V. 25 mm:
-
C‑TF trinocular tube F
-
C‑TT trinocular tube T (different port division options)
-
-
-
Nosepiece
-
Intelligent sextuple (6-position) nosepiece with analyzer slot for polarizing optics
-
-
Stage
-
Manual cross‑travel: 78 mm (X) × 54 mm (Y)
-
Vernier calibration included
-
Stage handle height and torque are adjustable
-
Specimen holder options: C-H2L (2‑slide), C-H1L (1‑slide), ceramic-coated versions
-
-
Condenser
-
Manual condenser with 27 mm focusing stroke
-
Condenser options:
-
C‑AB Abbe
-
C‑AR Achromat
-
C‑DO Oil Darkfield
-
C‑DD Dry Darkfield
-
C‑PH Phase Contrast Turret
-
C‑AA Achromat / Aplanat
-
C‑SA Slide Achromat 2–100×
-
C‑SW Swing-out Achromat 1–100×
-
C‑SWA Swing-out Achromat 2–100×
-
C‑LAR Long Working Distance Achromat
-
-
-
Observation Modes
-
Brightfield
-
Epi-fluorescence (with optional CI-FL‑2 or D-FL‑2 attachments)
-
Darkfield
-
Phase contrast
-
Simple polarizing
-
Sensitive color polarizing
-
-
Epi‑Fluorescence
-
Support for CI-FL‑2 (4 filter cubes) and D‑FL‑2 U‑EPI (6 filter cubes, terminator mechanism)
-
-
Power Consumption
-
~5.0 W in brightfield configuration
-
-
Weight
-
Approx. 13.3 kg (with standard binocular setup)
-
You can find complete, updated details on the manufacturer’s website:
[Visit Nikon official product page]
© 2025 Nikon plc. Used under authorization.
Product information sourced from Nikon Microscopes. All trademarks are the property of their respective owners.